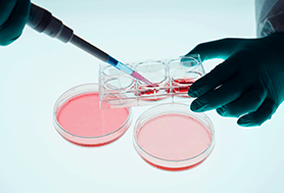
Protocols

High Quality Cell Culture Media and Auxiliary Reagents
Featured Product Categories
Providing Comprehensive, Custom Solutions Tailored to Your Specific Needs
Reagent Customization Services
Tailored Culture Media for Your Unique Research Needs
Key Features:
• Fast Turnaround
• Scalable Production
• Strict Quality Control
• ISO 9001 and ISO 13485 Certified
-
Complete Growth Media
Validated through proprietary cell bank cultivation to ensure reliability and performance. Available in small-volume packaging for convenient use.
→ -
Induced Differentiation Media
Optimized formulations to enhance adipogenic, osteogenic, and chondrogenic differentiation with high reproducibility and stable performance.
→
-
Growth Supplements
Provide essential nutrients to support diverse cell growth requirements, including specialized formulations such as B-27 for neural cell culture.
→ -
Primary Cell Isolation Kits
Effectively address the challenges of cell isolation and culture, ensuring high efficiency and reliability to advance primary cell research.
→
Resource Center
Expert Resources to Support Your Research Journey

Cell Culture Academy
Explore expert articles and tips for effective cell culture practices.
Learn MoreOur Strengths
What Sets Us Apart?

One stop Cell Culture Solution
• Contains cell culture medium, antibiotics, supplements, etc
• Cover the entire process of cell culture

Trusted Supplier of Cell Culture Products
• 20,000+ product citations
• Over 100 million cell culture validations

Quality Guarantee
100%
• Independently developed raw materials
• Complete quality control system

Professional and Convenient Services
• Global presence
• Worldwide delivery
• Expert technical support
Certification
Authorized Certifications and Industry Standards



About Procell
Procell Biotechnology Singapore Pte. Ltd., a leader in cell industry standards, is dedicated to providing high-quality cell culture products and services globally. Our offerings include cell culture media, buffer and balance salt, cryomedium, cell dissociation reagents, growth additives and other cell culture related reagents.